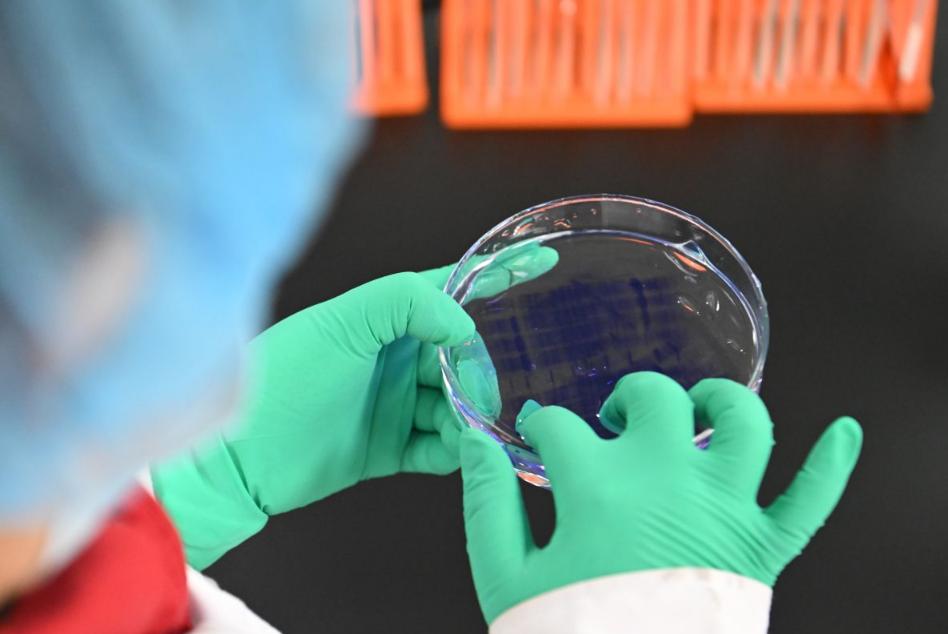

剑指“十五五”新引擎!中国43家生物制造平台落地,700亿出海成绩单加码 11月29日消息,中国将生物制造纳入“十五五”规划核心,工信部敲定首批43家生物制造中试平台,涵盖生物制药、化妆品等多领域,华熙生物、长春生物等龙头入围,旨在打通创新成果商业化“死亡谷”。 这些平台将按市场化原则提供有偿服务,目标2027年服务超200家企业、转化400余个商业产品,破解中小企业中试产能短缺难题。政策加持下,中国生物科技出海表现亮眼,2025年1-9月创新药全球授权交易额近700亿美元,较2021年暴涨8倍。 花旗、摩根大通等机构指出,生物制造已成中国经济核心增长极,此次布局既补全产业链短板、强化技术自主,也将助力中国在全球生物产业竞争中抢占先机,推动绿色低碳与高质量发展深度融合。